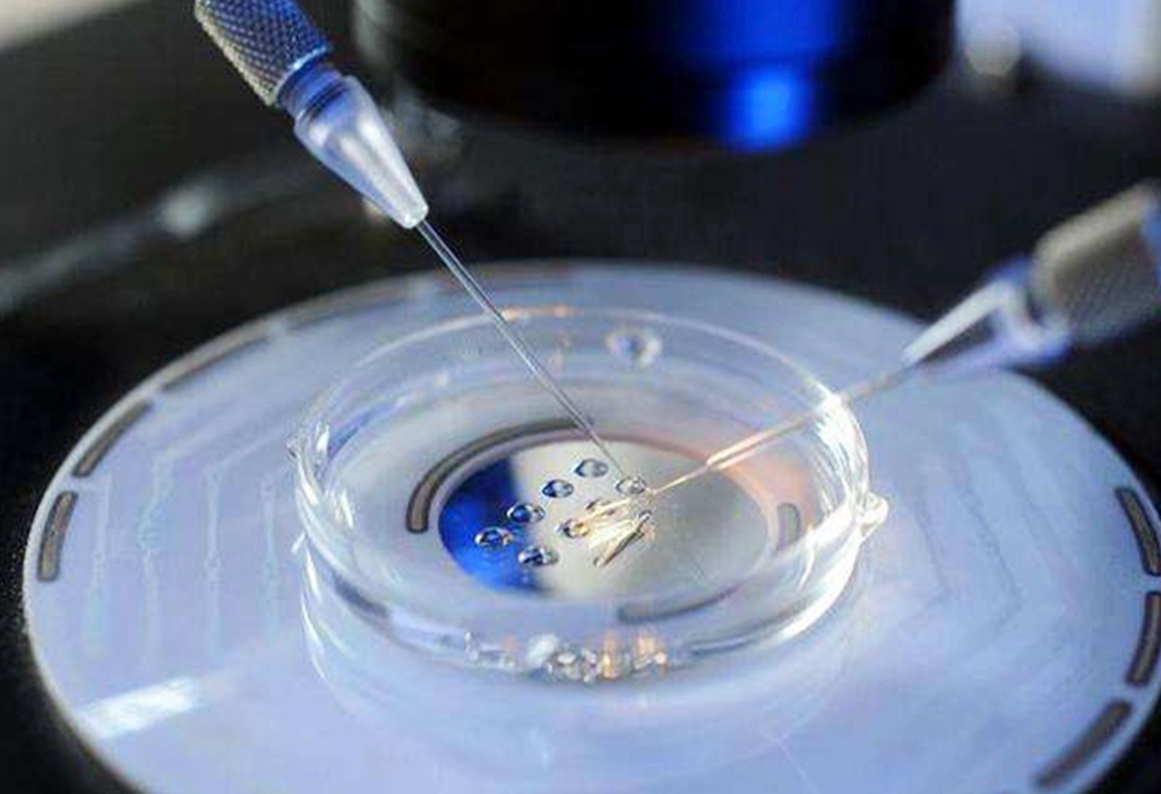

试管婴儿技术为许多不孕不育家庭带来了希望,而促排卵方案的选择则是试管婴儿成功的关键之一。那么,试管婴儿有多少个方案呢?我们又该如何正确选择促排卵方案呢?一、试管
试管婴儿技术为许多渴望拥有孩子的家庭带来了希望。在试管婴儿过程中,促排卵方案的选择至关重要。那么,试管婴儿有多少个方案呢?又该如何选择促排卵方案呢?一、试管婴儿
在理论上,促排卵治疗可能会加速女性的卵巢功能衰竭,并因此导致提前绝经。但是在实践中,这种情况并不常见。什么是提前绝经正常情况下,女性的卵巢大约在45-55岁左右
试管婴儿的促排卵阶段是迈向成功孕育的关键一步,在此期间,有许多需要注意的事项。一、饮食调整助力促排增加富含蛋白质食物的摄入蛋白质是身体细胞的重要组成部分,对于卵
试管婴儿技术为许多不孕不育家庭带来了希望,而促排卵阶段是其中的重要环节。那么,在试管婴儿促排卵期间有哪些注意事项呢?一、饮食方面均衡营养保证摄入均衡的营养对于促
试管婴儿技术为许多不孕不育家庭带来了希望,而促排卵针是其中的重要环节。那么,试管婴儿促排卵针究竟需要打多久呢?一、认识促排卵针的作用促排卵针的主要作用是刺激卵巢
对于许多踏上试管婴儿征程的夫妇来说,促排卵针是关键的一步。那么,试管婴儿促排卵针需要打多久呢?一、促排卵的目的与过程在试管婴儿过程中,促排卵的目的是刺激卵巢,使
试管婴儿技术为众多渴望拥有宝宝的家庭带来了新的希望,而促排卵阶段是实现这一希望的重要步骤。那么,在试管婴儿促排卵过程中究竟是怎么获得卵子的呢?一、前期准备与促排
试管婴儿技术为许多不孕不育家庭带来了希望,而促排卵是其中的关键环节之一。那么,在试管婴儿促排卵过程中是怎么获得卵子的呢?一、促排卵的目的与原理在自然月经周期中,
对于许多选择试管婴儿技术的夫妇来说,促排卵阶段是关键的一步。然而,在这个过程中,一些女性会发现自己的白带明显增多,这究竟是怎么回事呢?一、促排卵的生理机制与白带
热门推荐
猜你想搜
知识体系